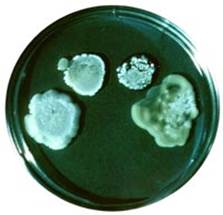

□文/图 院感办 骆春华 张梅
每年的10月15日是世界洗手日(Global handwashing day)。今年10月15日是第10个“全球洗手日”,其主题是“我们的手,我们的未来”。目的是呼吁大家通过“洗手”这个简单但重要的动作,达到加强卫生意识,改善卫生行为,预防感染性疾病的目的。
在日常生活中,工作、学习、生活都离不开手。自人类进化到现今阶段,所有活动均与手的动作直接相关。手创造了财富、科技、历史,但却在感染性疾病中是病菌的主要传播媒介。无数证据证明,正确的手卫生行为能最大程度上减少感染性疾病的传播。
自2008年首个全球洗手日发布以来,全球有70多个国家超过1.2亿儿童在用肥皂洗手,目的是降低例如腹泻和急性呼吸道感染等威胁生命的疾病发病率。如今,每年至少有350万五岁以下的儿童死于腹泻和呼吸道感染性疾病。用肥皂洗手的简单举动,特别是在如厕后及准备进食前的关键时刻用肥皂洗手,可将5岁以下儿童的腹泻发病率降低大约50%,呼吸道感染发病率降低近25%。儿童良好的洗手行为可影响他们家庭甚至社区。因此,积极的儿童参与,将伴随着以社区为基础的可持续的行为改变。
广医五院院感办倡导:让洗手成为一种习惯,让公众知晓肥皂洗手的好处,让大家一起正确地洗手。
标准七步洗手法

掌心相对、手指并拢、 手心对手背沿指缝相 掌心相对,双手交叉 弯曲手指使关节在另一
互相揉搓 互揉搓,交换进行 指缝互相揉搓 手掌心旋转揉搓,交换进行

左手握住右手大拇指 将五个手指尖并拢,放 一手旋揉搓另一手腕部、
旋转揉搓,交换进行 在另一手掌心旋转揉搓, 前臂,直至肘部;交替
交换进行 进行
注意:
1.每步骤至少来回洗五次
2.尽可能使用专业的洗手液
3.洗手时应稍加用力
4.使用流动的洁水
5.使用一次性纸巾或已消毒的毛巾擦手
以下是手的细菌对照实验及实验结果

未洗的手 漂洗的手(只用清水)

洗净的手(用皂液) 洗净的手(用消毒剂)






